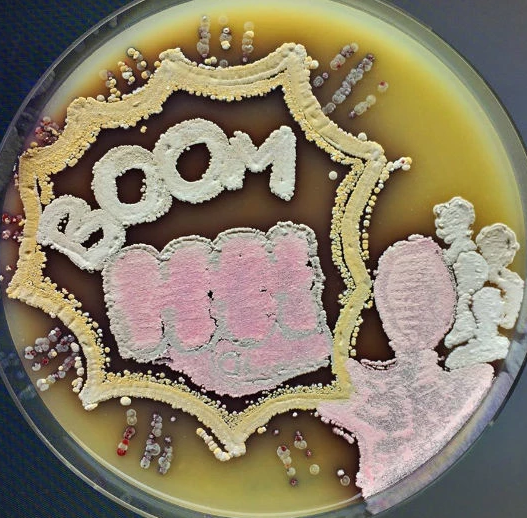
Photo
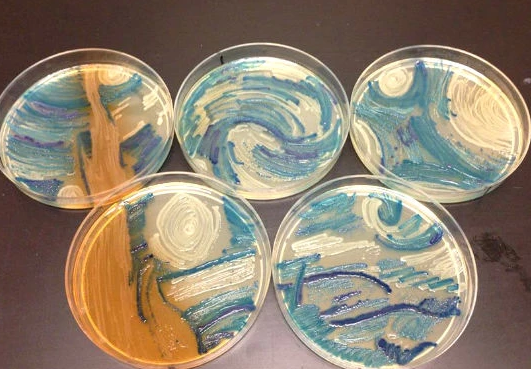
Photo
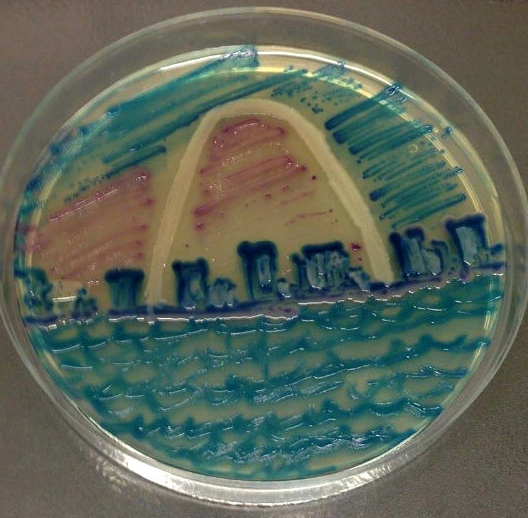
Photo
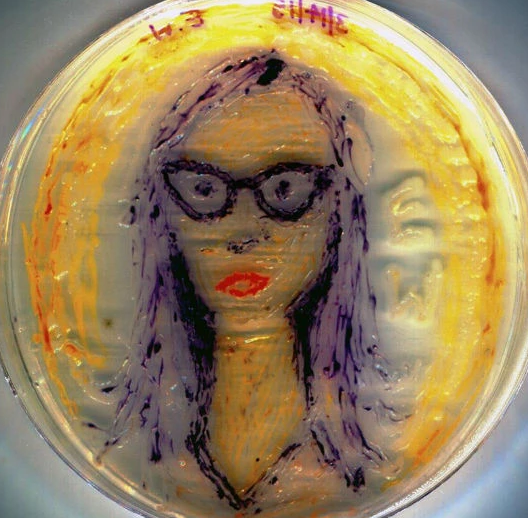
Photo

若提到科学家,你第一个想到的印象是什幺?这几年来,靠着漫威电影的“钢铁人”让社会大众暂时脱离了以往对科学家的刻板印象,诸如:不浪漫、没艺术感、成天待在实验室不出来的怪咖...等等。若不是天才又浪漫的东尼・史塔克,我想大家对科学家都还停留在《德克斯特的实验室》里的那个自恋神童吧?
▼嘣!那你就错了!为了让更多人知道其实他们也是有不为人知的艺术面,美国微生物学会的科学家们决定发起个比赛,相互较量看谁能做出最美丽的创作!
美国微生物学会(American Society for Microbiology)决定主办第一届细菌培养皿琼脂美术大赛,让所有参赛的科学家利用琼脂为画布,细菌为颜料,不设主题各自发挥实力,看谁能培养出最强大的艺术创作!经过激烈的评审阶段后,终于从85项作品中挑选出了其中几个最厉害的作品,按名次纷纷介绍如下:
前三名
▼1.“神经元Neurons”,由New England生化实验室的Mehmet Berkmen夺下

▼2.“纽约地铁地图”!Christine Marizzi是为社区实验室的讲师,她和社区成员合力完成了这幅由微生物菌种绘製而成的纽约地下道概图。她表示,“微生物太微小了,小到肉眼见不到,但它们确实生活在你我周遭世界的每一块角落。纽约市始终是个文化大熔炉,不论是人或微生物都一样,各种人和各种微生物都共同生活在这个大都会中,我们的生活会大大影响这些微生物的组成,而它们的组成更是大大地影响了我们的生活。”

▼3.“大丰收”由一名来到美国研读博士班的研究生Maria Eugenia Inda所获得。

▼还没结束呢!还记得刚刚上面首奖的那位作者Mehmet Berkmen吗?其实他的作品不只一个,相较于学会自己的审核,他的另个作品“细胞”虽然没有赢得评审的最高认可,却在脸书上获得到了最多的讚!这样他是不是等同赢得了两项首奖!

当然每个人的审美观都不同,虽然前三名获奖作品确实很厉害,但也有很多网民觉得审核不公平,其他作品里面有些作品更该值得获奖,而这些作品也确实真的很让人讚叹,让我们来看看几个佳作吧!
▼梵谷的“星空”经典重现!这个竟然没有得到头奖也是醉了...
▼这只蝴蝶也太逼真了吧!不说还以为是标本啊!

▼再来是,“圣路易市”!
▼…你老婆在你后面,她看起来很生气!但可以用细菌培养皿画出这幺精细的头像其实也是蛮屌的啦!
什幺!?这样就没了吗?放心,如果你还看不够的话,这里有準备了比赛的连结,让你好好看个够https://www.facebook.com/media/set/?set=a.10154367491515200.1073741836.62453295199&type=3结果已经出炉了,就算你不满意前三也来不及了!其实主办单位只是要证明,科学家们不是只会物理化学,死守实验室的呆板怪人,其实他们也可以是充满了浪漫的艺术家!为了让人看到他们工作之外令人惊人的一面,他们决定以后还要继续主办这个活动,让更多人看到他们的作品!你也可以帮他们,看完后分享出去吧!让更多人欣赏这些科学家的创作!
喜欢这篇文章吗?快分享吧!





